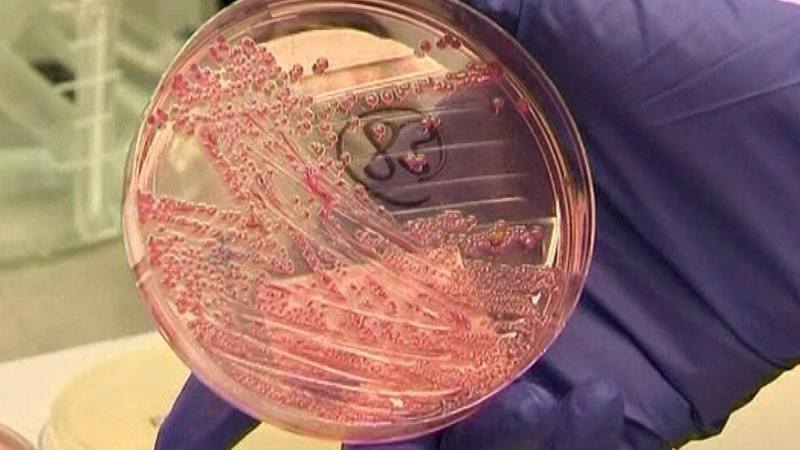
There were 200 cases of VTEC or E coli 026 reported in Ireland in 2010

A creche in Limerick has been asked to close by the public health department of the Health Service Executive as a result of an outbreak of E coli.
The strain of E coli has been identified as E coli 026, or VTEC.
Fewer than ten children have been infected; a number of linked cases have been identified.
The closure is to enable all staff and children attending the creche to be screened.
The HSE said it was satisfied that the creche was fully compliant with pre-school standards.
However, children from this creche will not be able to attend other child care facilities until they have been cleared of infection.
200 cases of VTEC or E coli 026 were reported in Ireland in 2010.
It can cause bloody diarrhoea and cramps, and sometimes has no symptoms at all. The incidence of the infection is high in children under five years old, as it is easily spread between young children.
It can be transmitted from person to person through contaminated water, through contact with farm animals, or by consuming undercooked meat or unpasteurised products. It is treated by drinking plenty of fluids.